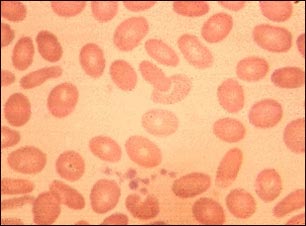
Ovalocitosis

![]() | ![]() | ![]() |
Ovalocitosis
Los glóbulos rojos de la sangre (GR) normalmente son redondos, pero en la ovalocitosis, estas células tienen una forma ovoide. Otras condiciones que producen alteraciones en la forma de los GR son la esferocitosis y la eliptocitosis.
Actualizado: 6/14/2008
